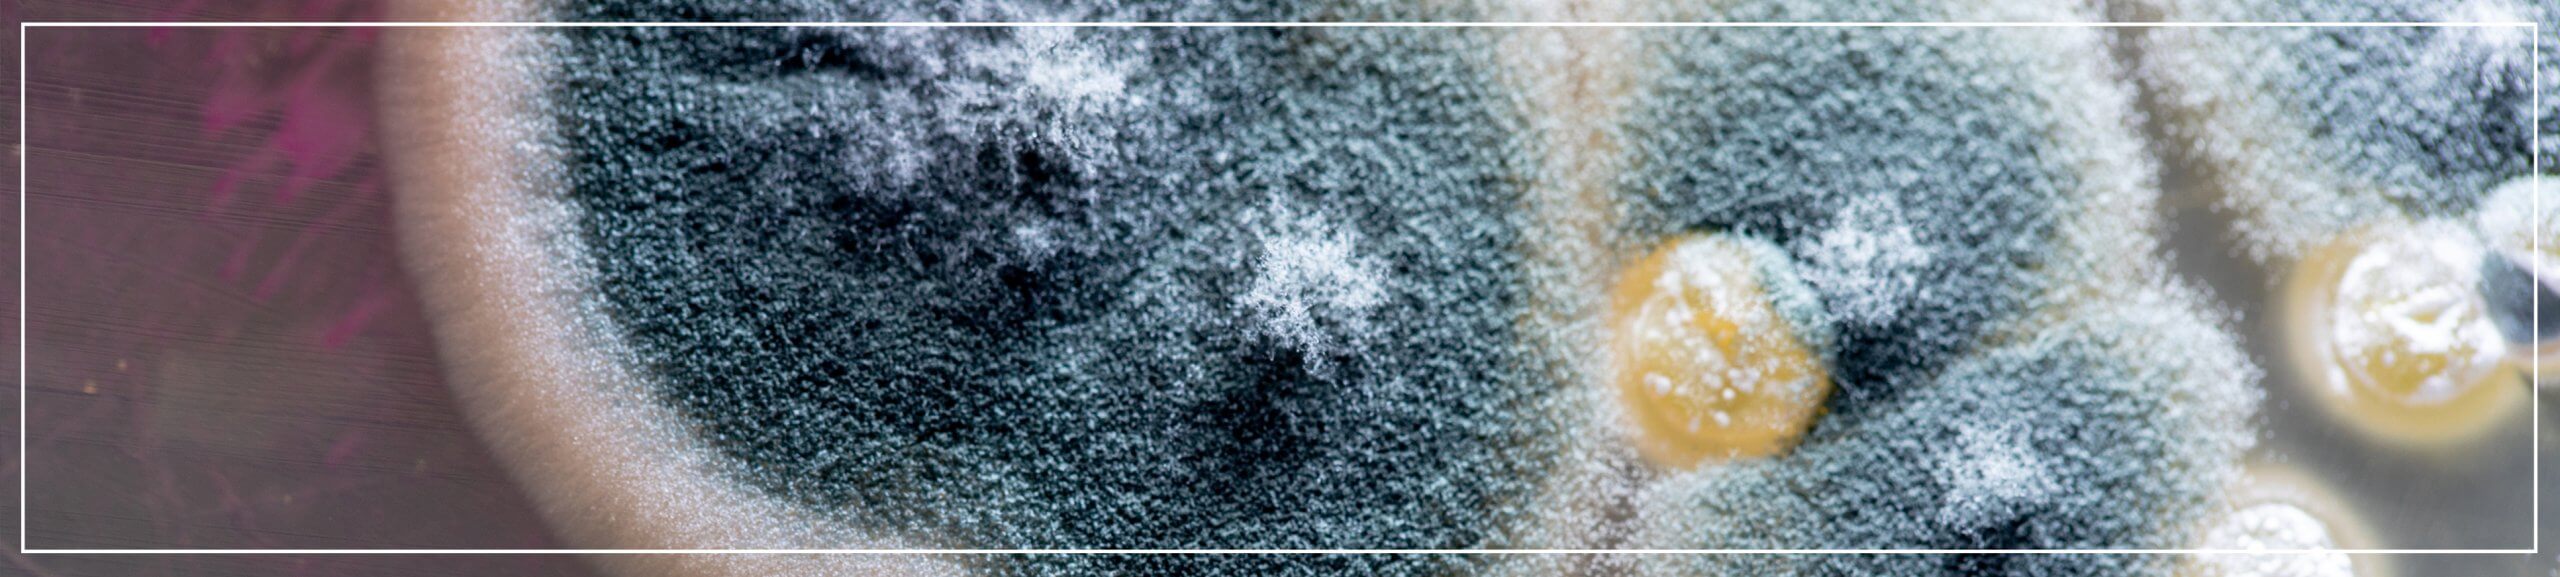
Fungal infections

It has been reported that there are more than 150 million cases of severe fungal infections worldwide with over one and a half million deaths.
The reasons that fungal infections are not considered at the outset is because they are commonly are a complication of another condition, in particular persons with immunosuppressive conditions.
The BBC reported on this subject in 2016, stating that fungal infections kill more people than malaria or breast cancer.

A more recent study found around one in six people who are admitted to intensive care with COVID-19 have invasive fungal infections.
The infections are more deadly in cancer patients, who are at extremely high risk of developing fungal infections and can be a significant factor in deaths involving cancer. If fungal infections are not treated and controlled at the outset it can become a major factor of deaths in people who are immunosuppressed.
Swift diagnosis and treatment is therefore critical in such cases, so as to avoid rapidly worsening conditions and even death in vulnerable patients.
Medical Misdiagnosis or Delay
Medical misdiagnosis and/or delay can severely affect an individual’s life, treatment options, recovery period and in more serious cases the chance of survival.
If you have been given the wrong medical advice or course of treatment which has left you in a debilitating condition, you may be eligible to make a medical misdiagnosis and/or delay claim. More detailed information about this aspect of medical negligence can be found here.
WHAT TO DO NEXT
If you believe you have suffered due to medical misdiagnosis or delay, get in touch today for a no-obligation consultation or for an update about the progression of a claim.
Choose one of the methods on the right-hand side of this page, or call us on 0113 200 9720 to find out how we can help you.
It has been reported that there are more than 150 million cases of severe fungal infections worldwide with over one and a half million deaths. The reasons that fungal infections are not considered at the outset is because they are commonly are a complication of another condition, in particular persons with immunosuppressive conditions. The…
Medical Negligence Team – Case Studies Showcase
Here is a collection of recent case studies from our Medical Negligence department, showcasing not only the variety of matters they help to resolve, but also the figure awarded to the client upon …
View
Ulcer and Sepsis – Case Study
Our client received medical treatment in June 2016. After attending her GP with symptoms, she was admitted to hospital as these had progressed to be more severe.
It was noted by me…
View
Preventing Bedsores
Without due care and attention, bedsores can develop quickly for patients who are restricted from movement for large amounts of time. Preventing bedsores can often be critica…
View